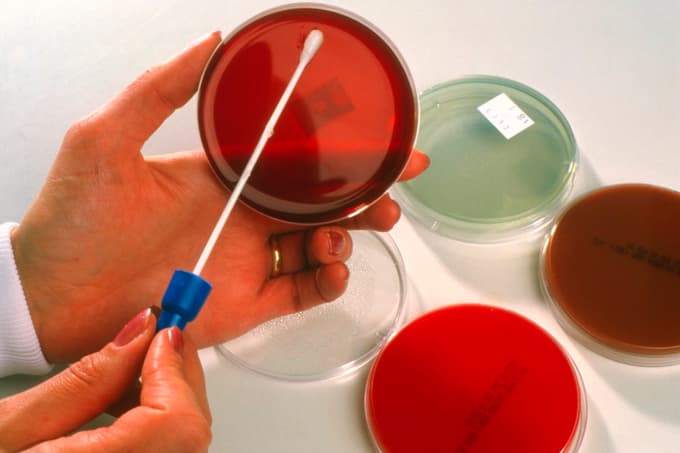
Huawei ostaja vodilni glede na število prijavljenih patentov pri Evropskem patentnem uradu

Evropski patentni urad (EPO) je objavil podatke o prijavah patentov v letu 2023 in potrdil, da so podjetja in izumitelji lani vložili rekordno število patentnih prijav. Že tretje leto zapored jih je največ prijavil Huawei. Podjetja in izumitelji so lani na EPO vložili 199.275 patentnih prijav, za 2,9 odstotka več kot leto prej, predvsem zaradi pospeška inovacij na področjih digitalne in zelene transformacije.
Največ prijav je bilo prav na področju digitalnih komunikacij, ki zajema tehnologije povezane z mobilnimi omrežji, sledita medicinska in računalniška tehnologija, pa električni stroji in aparati ter energija, na petem mestu pa so patenti s področja meritev. Od šestega do desetega mesta se vrstijo področja transporta, farmacije, biotehnologije, drugih specializiranih strojev in organske fine kemije.
Največja rast patentov na področju strojev in energije
Kar osem od desetih najbolj patentno aktivnih področij je zabeležilo rast, so objavili pri EPO. Najhitreje so rasli električni stroji in aparati ter energija (+12,2 odstotka), gre za področje, ki vključuje izume čiste energije in baterijske tehnologije. Najboljše tehnološko področje digitalnih komunikacij (+8,6 odstotka) je zabeležilo močno rast, prav tako biotehnologija (+5,9 odstotka).
Prijave so ostale močne na področju medicinske tehnologije (+1,3 odstotka), računalniške tehnologije (+1,2 odstotka) in meritev (3,5 odstotka), ki vključuje senzorje, ki so ključnega pomena za funkcije številnih pametnih naprav. Skupno število vlog na prvih desetih področjih je leta 2023 predstavljalo 57 odstotkov vseh evropskih patentnih prijav.
Huawei na vrhu že tretje leto zapored
Kitajski Huawei torej ostaja vodilni glede na število prijavljenih patentov pri Evropskem patentnem uradu. Poročajo, da so lani vložili 5071 patentov, kar je 12,6 odstotka več kot leto prej. Sledi mu južnokorejski Samsung s 4760 prijavljenimi patenti in 59,3 odstotnim povečanjem vlog, tretji pa je prav tako južnokorejski LG, ki je vložil 3498 patentov, to pa je bilo 0,3 odstotka manj v primerjavi z letom 2022. Top peterico po številu patentov zaključujeta Qualcomm (3275, +10,4 odstotka) in Ericsson (1969, +7,8 odstotka). Pri EPO so zapisali, da nastajajo nove sinergije, ki presegajo posamezna področja, pogosto jih vodijo umetna inteligenca in potreba po čistejših ter energijsko učinkovitejših rešitvah.
Geografsko gledano so vloge evropskih vlagateljev stalno rasle (+1,8 odstotka) in lani dosegle delež v skupni vrednosti 43 odstotkov. Še naprej vodijo nemški prijavitelji z 12,5 odstotka vseh, znatno povečanje so opazili na Finskem (+9,2 odstotka), v Španiji (+6,9 odstotka), Združenem kraljestvu (+4,2 odstotka), Italiji (+3,8 odstotka) in na Nizozemskem (+3,5 odstotka). Sicer pa so bile med petimi največjimi državami izvora vlog v letu 2023 Združene države Amerike, ki predstavljajo skoraj četrtino vseh vlog (24,2 odstotka), sledijo Nemčija (12,5 odstotka), Japonska (10,8 odstotka) in Kitajska (10,4 odstotka) ter Južna Koreja (6,6 odstotka). Švica je ostala država z največ patentnimi prijavami na prebivalca.
Skoraj vsako četrto vlogo vloži majhno podjetje
Patenti so zelo pomembni tudi za mala podjetja. Tako je leta 2023 kar 23 odstotkov patentnih prijav pri EPO, ki izvirajo iz Evrope, vložil posamezni izumitelj ali malo oziroma srednje veliko podjetje (z manj kot 250 zaposlenimi). Nadaljnjih 8 odstotkov jih je prišlo z univerz in javnih raziskovalnih organizacij. Kot del stalne podpore manjšim subjektom je EPO napovedal nova znižanja pristojbin s 1. aprilom 2024 za mikropodjetja, posameznike, neprofitne organizacije, univerze in javne raziskovalne organizacije.
V središču pozornosti so tudi izumiteljice. Letošnji patentni indeks namreč obravnava tudi prispevek žensk k inovacijam. Za vse patentne prijave, vložene pri EPO lani iz Evrope, so vlagatelji pri 27 odstotkih navedli vsaj eno žensko kot izumiteljico. Med večjimi evropskimi patentnimi prijavami (z več kot 2000 prijavami na leto) so imele Španija (46 odstotkov), Francija (33 odstotkov) in Belgija (32 odstotkov) največji delež patentnih prijav, v katerih je kot izumiteljica navedena vsaj ena ženska.